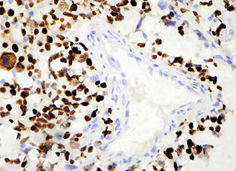
市售p53,克隆号:SP5

兔单克隆抗体技术简介:
单克隆抗体是来源于单一B细胞的抗体,这种抗体只能识别单一的抗原分子。70年代中期Khler和Milstein创造了单个鼠B细胞和骨髓瘤细胞融合的鼠杂交瘤细胞技术,并因此获得了1984年度诺贝尔医学奖。杂交瘤细胞(Hybridomas)可以产生无穷的单克隆抗体。1995年,Katherine Knight博士在美国芝加哥Loyola大学成功地从转基因兔中获得了骨髓瘤细胞(Plasmacytoma),开创了兔单克隆抗体技术并申请了专利。其后几年里,加州大学旧金山分校医学院Robert Pytela 博士和朱伟民将此技术进行了改进,使之能大量生产兔单克隆抗体。2003年,Epitomics公司买断了兔单克隆抗体技术专利,成功地开发了兔单克隆抗体用于科研、诊断和治疗的技术平台。深达公司在2006年获得了兔单抗专利产品的授权,在国内开发生产兔单抗免疫组化试剂系列产品。
与鼠单抗相比,兔单抗具有以下的优势:
首先,兔抗血清通常含有高亲合力抗体,可以比鼠抗血清识别更多种类的表位;
其次,兔单克隆抗体能够以识别许多在小鼠中不产生免疫的抗原;
第三,由于兔脾脏较大,可以进行更多的融合实验,使得高通量筛选融合细胞成为可能。
兔单克隆抗体作为诊断产品:
长期以来,兔免疫系统为研究诊断工作提供了优良的抗体试剂。 许多小分子化合物和多肽在兔体内能够产生有效的免疫反应。因此,兔多克隆抗体一直用于药物筛选和临床诊断。兔单抗技术则通过生产高质量的兔单抗产品,为研究和临床工作提供比兔多抗更优良的诊断试剂,其特异性更高,本底更低。
下面为中山大学附属第一医院病理科使用本公司生产的p53兔单抗(左)与市售兔单抗产品(右)的免疫组化检测效果对比:
与市售同类产品相比,本公司所生产的兔单抗产品在阳性着色强度和显色背景方面都表现出了优良的使用性能。
抗体详细信息可点图片查看!
|

